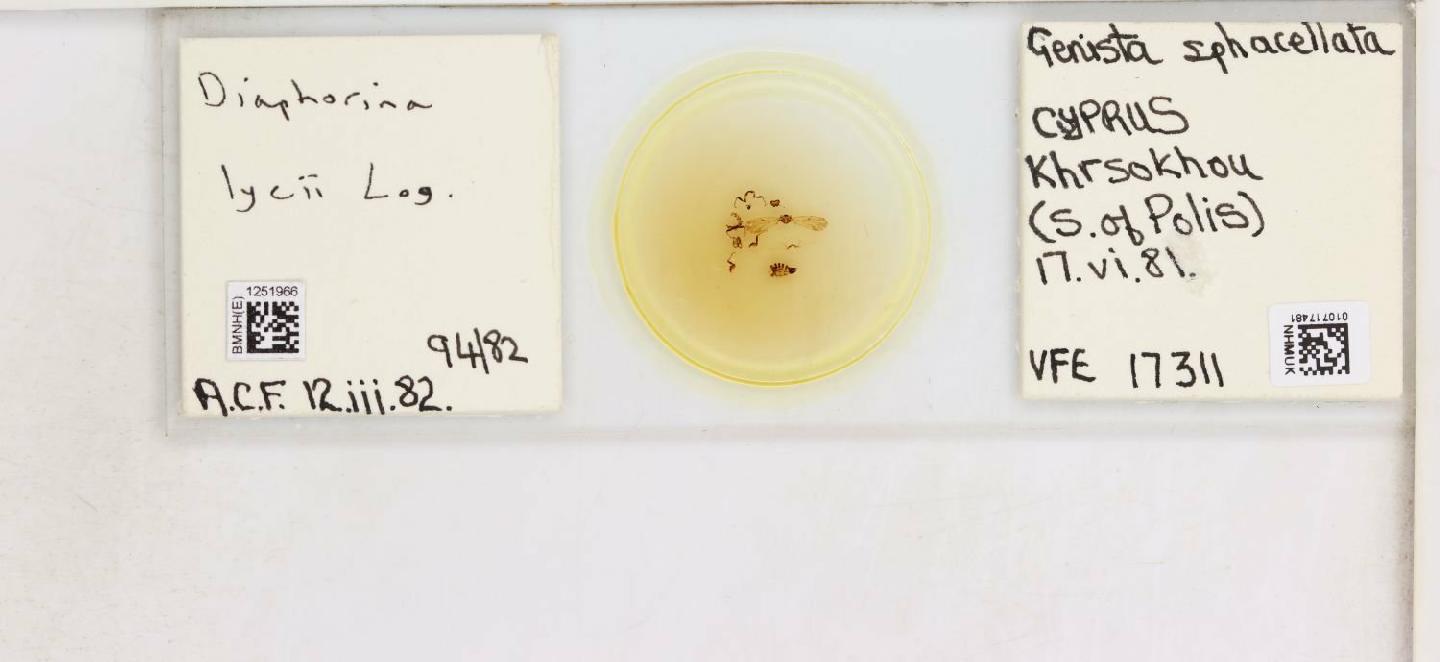
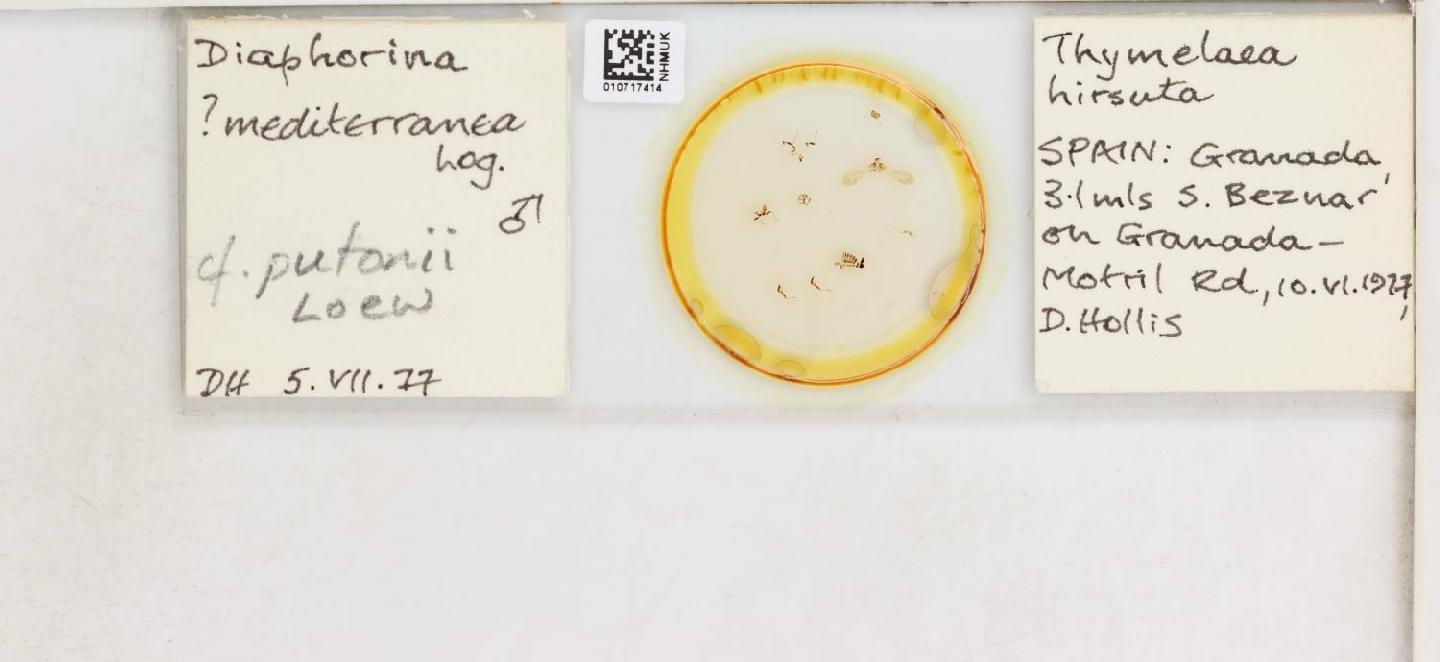

Espèces 2529 à 2544 sur 2929
Craspedolepta sonchi
Foerster, 1848
8 occurrences
8 medias

Craspedolepta subpunctata
Foerster, 1848
47 occurrences
47 medias

Ctenarytaina eucalypti
Maskell, 1890
254 occurrences
254 medias

Ctenarytaina peregrina
Hodkinson, 2007
26 occurrences
26 medias

Ctenarytaina spatulata
Taylor, 1997
48 occurrences
48 medias

Cyamophila prohaskai
Priesner, 1927
2 occurrences
2 medias

Diaphorina lycii
Loginova, 1978
13 occurrences
13 medias
Diaphorina putonii
Löw, 1879
16 occurrences
16 medias
Euphyllura olivina
Costa, 1839
136 occurrences
136 medias

Euphyllura phillyreae
Foerster, 1848
59 occurrences
59 medias

Lisronia varicicosta
Hodkinson & Hollis, 1981
6 occurrences
6 medias

Livia crefeldensis
Mink, 1855
4 occurrences
4 medias

Livia junci
Schrank, 1789
493 occurrences
493 medias

Livia mediterranea
Loginova, 1974
1 occurrences
1 medias

Livilla bimaculata
Hodkinson & Hollis, 1987
15 occurrences
15 medias

Livilla cataloniensis
Hodkinson & White, 1979
28 occurrences
28 medias
